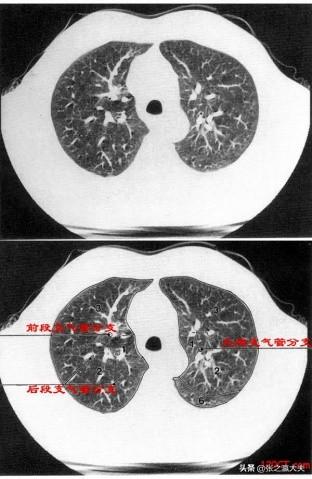

Quel est le problème avec le cancer du poumon ?
Quel est le problème avec le cancer du poumon ?
Qu'y a-t-il de mal à ce que les personnes atteintes d'un cancer du poumon soient très capables de manger ? La raison pour laquelle une telle question se pose reflète en fait un concept profondément ancré dans l'esprit de nombreuses personnes, à savoir que les personnes atteintes d'un cancer ne doivent pas pouvoir manger ou manger très peu, qu'elles doivent être jaunes et maigres, qu'elles ne doivent pas ressembler à des êtres humains, et qu'elles doivent l'être. Bref, il y a toutes sortes de mauvaises imaginations. Il y a deux types de personnes qui ont ce genre de concept : l'une d'elles pense qu'elle a réellement vu ce type de patients atteints de tumeurs, par exemple, les membres de sa famille et ses proches qui ont un cancer ont été dans une telle situation, et elle fait donc une généralisation et traite les cas ou les quelques patients qu'elle a vus comme s'il s'agissait de tous les patients qui doivent être comme cela, et ce genre de conclusion qui consiste à lancer tout le groupe à partir de cas individuels est forcément erronée. Un autre type de personne est celle qui n'a jamais vu de ses propres yeux un patient atteint d'un cancer, et qui le fait uniquement sur la base de ce qu'elle a entendu dire par d'autres, ce que l'on appelle des ouï-dire.
Je pense que les patients en oncologie ou les membres de leur famille qui en ont fait l'expérience hocheront la tête en signe d'assentiment, car il est vrai que de nombreux patients atteints de cancer ne sont pas aussi incapables de manger ou de manger moins que nous l'imaginons tous, ou qu'ils doivent être jaunâtres et maigres. Bien sûr, il faut noter que je ne dis pas que tous les malades du cancer ne doivent pas être jaunâtres et maigres et qu'ils doivent tous manger normalement. Ce que je dis, c'est qu'il ne faut pas tomber dans l'extrême, car les malades du cancer constituent un groupe très large avec des pathologies très diverses, donc comment faire une généralité ? Pour ceux qui n'ont pas de cancer, on ne peut pas dire qu'ils mangent tous normalement et qu'aucun d'entre eux n'est jaune et maigre.
Quel est le problème si les patients atteints de cancer du poumon peuvent très bien manger ? Il est vrai que certains patients ne peuvent pas manger, mangent moins et sont jaunâtres et maigres, mais cela ne signifie pas que tous les patients atteints d'un cancer du poumon sont comme cela, certains d'entre eux peuvent n'avoir aucun malaise, et comme les gens normaux, vous ne pouvez pas le voir du tout, et certains d'entre eux ont même l'air plus énergique que les personnes dites en bonne santé. Bien sûr, si vous avez un cancer du poumon, si vous ne le traitez pas à temps et que vous le laissez se développer, tôt ou tard cela ne marchera pas.
Le cancer du poumon est le type de cancer le plus fréquent dans notre service d'oncologie. Au maximum, il y a environ la moitié des patients atteints de cancer du poumon dans un service, et parmi eux, le cancer du poumon non à petites cellules est le plus courant, comme l'adénocarcinome pulmonaire et le cancer du poumon malpighien. En fait, les patients atteints de cancer du poumon qui viennent dans notre service d'oncologie sont essentiellement des patients en phase avancée (ceux qui ont une chance de bénéficier d'un traitement chirurgical à un stade précoce ou moyen sont opérés)👇👇👇👇👇👇.
Ces patients vont essentiellement subir une radiothérapie et une chimiothérapie. Comme nous le savons tous, la radiothérapie et la chimiothérapie ont plus ou moins d'impact sur le système digestif, de sorte que les patients qui suivent un traitement antitumoral pour le cancer du poumon ont généralement peu d'appétit, et il est relativement rare qu'ils soient capables de manger comme le dit le titre.Pourquoi les patients atteints d'un cancer du poumon peuvent-ils manger ?
I. Stade précoce du cancer du poumon.
Dans le passé, il semble que les symptômes des patients atteints de cancer du poumon soient plus graves, comme la toux, l'expectoration de sang, l'amaigrissement jaunâtre des muscles, la perte d'appétit, voire le gonflement du visage et des pieds, et la difficulté à respirer. Toutefois, il s'agit là des symptômes de patients atteints d'un cancer du poumon à un stade avancé, voire en phase terminale. En fait, grâce à l'amélioration du concept de santé publique, le cancer du poumon est détecté de plus en plus tôt. De plus en plus de patients sont diagnostiqués avec un cancer du poumon à un stade précoce. Ces personnes n'ont pratiquement aucun symptôme, alors comment savent-elles qu'elles ont un cancer du poumon ? Cet examen tomodensitométrique peut détecter certains petits nodules malins plus tôt que les radiographies du thorax.
Deuxièmement, le traitement a peu d'effets secondaires.
Lorsque l'on évoque la chimiothérapie pour les tumeurs, l'image de patients assis au chevet de leur lit et "vomissant" peut apparaître dans l'esprit de beaucoup de gens. À vrai dire, les vomissements, la perte d'appétit et les autres réactions du tube digestif provoqués par la chimiothérapie ont été considérablement améliorés ! Les effets secondaires de la chimiothérapie sont aujourd'hui beaucoup moins importants qu'auparavant. Sur le plan clinique, on s'efforce aujourd'hui de réduire le problème des effets secondaires toxiques chez les patients traités par des thérapies antitumorales. Par exemple, si un médicament antinéoplasique peut provoquer des vomissements, nous donnons au patient des médicaments pour prévenir les vomissements à l'avance ; si le patient a peu d'appétit, nous lui donnons des médicaments pour améliorer son appétit. En bref, les effets secondaires toxiques possibles sont prévus à l'avance et des interventions sont effectuées en temps utile !
En outre, outre la chimiothérapie, le traitement médicamenteux du cancer du poumon comprend désormais des thérapies ciblées et des thérapies d'immunothérapie.
Ces traitements affectent moins le système digestif que la chimiothérapie traditionnelle. Par conséquent, les patients atteints de cancer du poumon ne doivent pas s'inquiéter outre mesure de leur appétit. Il est encore temps de manger et de boire pendant le traitement antitumoral.
Le cancer du poumon est un type de cancer dont beaucoup d'entre nous ont entendu parler. Dans l'esprit de la plupart des gens, le cancer provoque une peau jaunâtre et de la fatigue, ce qui est effectivement le cas, mais cela se produit généralement à un stade avancé du cancer. Lorsque le cancer du poumon atteint un stade précoce, les patients ne présentent généralement aucun symptôme, et certains d'entre eux sont même découverts involontairement lors d'examens médicaux, alors qu'une détection et un traitement précoces permettent un meilleur pronostic. Lorsque le cancer du poumon atteint un stade avancé, des métastases apparaissent, notamment au niveau du foie, du cerveau, du système squelettique, du pancréas et d'autres organes, ce qui affecte gravement le régime alimentaire du patient et la maladie maligne.
Nous sommes à une époque où le niveau de vie économique augmente rapidement, nous sommes aussi à une époque où l'incidence du cancer est élevée, nous sommes à une époque où le cancer nous fait peur, mais nous avons encore trop d'inconnues sur le cancer, et nous avons encore beaucoup de chemin à parcourir pour vaincre le cancer, c'est-à-dire notre impuissance. En fait, chaque époque a sa propre joie et son propre désarroi. C'est ce genre de joie et d'impuissance qui fait que la vie est différente.
Le cancer du poumon, un type de cancer bien connu, est encore relativement fréquent dans notre entourage, avec la présence de nodules pulmonaires ou le diagnostic de cancer du poumon. Les données épidémiologiques montrent que le cancer du poumon est l'une des tumeurs malignes dont la morbidité et la mortalité augmentent le plus rapidement dans le monde, et que le taux de mortalité est le plus élevé parmi les tumeurs malignes. Les causes du cancer du poumon ne sont pas encore totalement élucidées, mais un grand nombre de données montrent que le tabagisme et la pollution environnementale sont les principaux facteurs de développement du cancer du poumon.
Nous avons l'impression que les patients atteints de cancer du poumon, ou tous les patients atteints de cancer, sont maigres, faibles et ne peuvent que rester au lit et se faire soigner par d'autres. En réalité, tous les patients atteints de tumeurs ne sont pas comme cela, et il existe également une grande différence dans l'appétit des patients atteints de tumeurs à différents stades de la maladie. En effet, certains patients atteints d'un cancer du poumon à un stade avancé de la maladie, en raison de l'augmentation de la charge tumorale et de certains effets secondaires causés par la radiothérapie, etc. peuvent effectivement souffrir d'une perte d'appétit. Par conséquent, les patients atteints de tumeurs, à différents stades de la maladie, peuvent avoir un meilleur appétit et être tout à fait capables de manger, ou ils peuvent souffrir de nausées, de vomissements, d'une perte d'appétit, etc. Par conséquent, les patients atteints de cancer du poumon qui sont tout à fait capables de manger constituent une situation clinique courante, ce qui prouve que l'état du patient n'est pas encore très mauvais.
Le Dr Zhang souhaite également souligner que de nombreux patients souffrent de nausées et d'une perte d'appétit après la chimiothérapie, et qu'à ce moment-là, nous devrions prêter attention à un régime alimentaire scientifique et raisonnable. Voici quelques suggestions tirées de la littérature concernant le régime alimentaire des patients atteints de cancer du poumon, que le Dr Zhang a extraites ici pour votre référence : nous devons comprendre et respecter pleinement les habitudes alimentaires des patients, leurs goûts personnels, leur état nutritionnel, etc., et élaborer des programmes alimentaires scientifiques et raisonnables en collaboration avec les médecins, les infirmières, les patients et les membres de leur famille ; nous devons également adhérer au principe de diversification alimentaire et consommer des aliments riches en vitamines et en protéines ; boire >2500 ml d'eau par jour ; consommer des aliments contenant des fibres brutes ; consommer des aliments contenant des fibres brutes ; consommer des aliments contenant des fibres brutes ; et consommer des aliments contenant des protéines élevées. Boire plus de 2500 ml d'eau par jour ; consommer des aliments contenant des fibres brutes et des laxatifs pour prévenir la constipation ; espacer autant que possible les repas et la chimiothérapie de plus de 3 heures, pour éviter les nausées, les vomissements et d'autres désagréments, etc.
En fait, nous avons quelques impressions inhérentes aux patients atteints de cancer du poumon, et chaque patient atteint de cancer sera différent, par exemple, les mêmes patients atteints de cancer du poumon peuvent avoir une période de survie très différente ; les mêmes patients atteints de cancer du poumon peuvent avoir un plan de traitement très différent ; les mêmes patients atteints de cancer du poumon peuvent avoir une réponse très différente au même plan de traitement ; les mêmes patients atteints de cancer du poumon peuvent avoir une réponse très différente au même plan de traitement ; et les mêmes patients atteints de cancer du poumon peuvent avoir un appétit très différent. Il est également très fréquent que leur appétit varie considérablement. Si vous pouvez manger, vous devez quand même manger, après tout, le cancer est une maladie de consommation, le corps humain normal et les cellules tumorales ont tous deux besoin d'absorber des nutriments.
Ce qui précède est ce que le Dr Zhang a pensé de ce sujet, les points de connaissance sur la situation alimentaire des patients atteints de cancer du poumon, j'espère que cela peut vous aider.
En effet, la croissance illimitée de ce tissu cancéreux se caractérise par un besoin important en nutriments, et le taux d'absorption de nutriments et d'énergie par les patients à partir de la nourriture ne peut tout simplement pas compenser l'appauvrissement causé par la croissance de la tumeur, d'où l'amaigrissement et l'affaiblissement ;
Par exemple, au premier stade du cancer, bien que la tumeur consomme également l'énergie et les nutriments de l'organisme, dans l'ensemble, les nutriments et l'énergie absorbés par le patient sont bien plus importants que ceux consommés par la tumeur, et dans cet état, la plupart des patients atteints de cancer ne souffriront pas d'une perte de poids trop importante, mais, bien sûr, cet état ne durera pas longtemps, et il changera au fur et à mesure que la tumeur grandira. et il changera au fur et à mesure que la tumeur continuera à se développer ;
En outre, les patients atteints de cancer à ce stade craignent d'avoir déjà commencé à souffrir d'anorexie et d'autres symptômes sous l'effet de la chimiothérapie et d'autres traitements, et les patients, qui ont déjà consommé de plus en plus sous l'influence de la tumeur, ont maintenant même des difficultés à manger, de sorte qu'il est étrange pour eux de ne pas être gaspillés ;
Toutefois, au stade précoce du cancer, lorsque la tumeur commence à se développer dans le corps du patient, les caractéristiques de croissance prédatrice des cellules cancéreuses augmentent considérablement le fardeau de l'organisme. Afin de résoudre ce dilemme, l'organisme a besoin de plus d'énergie et de nutriments, ce qui incite le patient à manger une grande quantité de nourriture, d'où la situation du patient mangeant une grande quantité de nourriture au stade précoce du cancer, qui varie bien sûr d'une personne à l'autre, et tous les patients atteints de cancer ne deviennent pas aussi capables de manger !
Mon expérience personnelle est qu'un an avant le diagnostic du cancer du poumon, mon appétit était de plus en plus mauvais, et lorsque je voyais de la viande, je régurgitais, et avant et après le diagnostic, mon appétit atteignait un cinquième de la quantité normale de nourriture. Cependant, après avoir pris le médicament ciblé, mon appétit a considérablement augmenté, je veux manger du porc braisé et des côtelettes d'agneau, et mon poids a augmenté de plus de dix livres en un an, et je m'inquiète maintenant de perdre du poids. Est-il possible que les médicaments ciblés contiennent des hormones ?
Mon père est mort d'un cancer du poumon, il a beaucoup fumé toute sa vie, mais son appétit n'en a jamais été affecté, il mangeait à la hâte et s'en est sorti sans même avoir maigri. Depuis le moment où il a été diagnostiqué jusqu'à la fin, il a toujours été capable de manger. Je pense donc que le cancer du poumon devrait être la maladie de la consommation dans l'ancienne société. Après avoir contracté cette maladie, le corps consomme beaucoup de nutriments, il a donc besoin de plus de nutriments, et il est donc particulièrement capable de manger. Les gens devraient donc arrêter de fumer, ne pas fumer, la cigarette est trop nocive pour la santé, elle transforme les poumons en charbon.

Le cancer, pour nous, c'est sans aucun doute un coup de tonnerre, et si possible, nous aimerions tous en être débarrassés pour le reste de notre vie. Seulement, notre vie ne se déroule pas comme nous le pensons, et il en va de même pour notre santé : le cancer nous tombe dessus sans crier gare. Parmi de nombreux cancers, l'incidence du cancer du poumon est significativement plus élevée que celle des autres cancers, et le taux de mortalité du cancer du poumon est également le plus élevé parmi les tumeurs désagréables.
Les causes du cancer du poumon sont nombreuses, et parmi les facteurs de morbidité connus, la pollution environnementale et le tabagisme sont des facteurs de morbidité importants. Souffrir d'un cancer du poumon équivaut également à être condamné à mort, et la vie s'arrêtera brutalement à un moment ou à un autre. Certaines personnes peuvent choisir de suivre une chimiothérapie, tandis que d'autres peuvent simplement renoncer au traitement et essayer de passer le plus de temps possible avec leur famille dans les dernières heures de leur vie.
Pour ce qui est de la capacité à manger après avoir souffert d'un cancer du poumon, cela varie en fait d'une personne à l'autre. À différents stades du cancer du poumon, les performances sont différentes. Par exemple, au stade avancé du cancer du poumon, l'impact du cancer du poumon sur le corps humain est plus grave, et la chimiothérapie affecte également l'appétit, et certains patients atteints de cancer du poumon n'ont même pas d'appétit du tout, et ne peuvent que se forcer à manger un peu.
Certains patients atteints d'un cancer du poumon montrent également qu'ils sont plus aptes à manger, ce qui est en fait un bon signe. En effet, lorsqu'une personne a un bon appétit, les nutriments contenus dans les aliments peuvent également pénétrer dans l'organisme pour le renforcer et l'aider à lutter contre le cancer du poumon. Pour les patients atteints de cancer du poumon, bien que le temps qu'il leur reste à vivre commence à se compter en jours, ils doivent coopérer activement au traitement.
Il est important d'adopter un régime alimentaire varié, composé d'un maximum d'aliments. Après tout, aucun aliment au monde ne peut contenir tous les nutriments dont le corps humain a besoin. Les patients atteints de cancer du poumon doivent augmenter leur consommation d'aliments riches en protéines, tels que les produits à base de soja, ou ajouter des protéines en poudre pour répondre aux besoins de l'organisme en protéines. Les vitamines sont des nutriments dont l'organisme ne peut se passer, et les patients atteints de cancer du poumon devraient également augmenter leur consommation de nutriments antioxydants pour résister aux effets néfastes du cancer du poumon.
Les patients atteints d'un cancer du poumon ont, à différents moments, des plans de traitement différents. Le régime alimentaire varie également beaucoup et tente de répondre aux besoins des patients atteints de cancer du poumon. Le traitement doit également respecter l'opinion du patient en fin de vie, afin qu'il puisse vivre ses derniers jours avec un peu plus de bonheur.
Le cancer du poumon devrait être connu de tous, et le taux d'incidence est très élevé chaque année. Nous devons donc accorder plus d'attention à notre propre santé et découvrir le problème pour le traiter à temps. Nous devons donc être plus attentifs à notre propre santé et découvrir le problème pour le traiter à temps, afin de ne pas nous mettre en danger, ce qui est très défavorable à notre santé.

Quel est le problème avec le cancer du poumon ?
Les causes du cancer du poumon ne sont pas encore totalement élucidées, mais un grand nombre de données montrent que le tabagisme et la pollution environnementale sont les principaux facteurs de développement du cancer du poumon.
En fait, tous les patients atteints de cancer du poumon ne sont pas comme ça, car la tumeur est à des stades différents et les conditions montrées par les patients seront différentes, donc leur appétit sera également différent.
Certains patients atteints d'un cancer du poumon à un stade avancé n'ont généralement pas beaucoup d'appétit en raison des effets secondaires de la radiothérapie, de l'augmentation de la taille de la tumeur ou de la propagation des métastases.
Certains patients atteints d'un cancer du poumon à un stade précoce peuvent avoir un appétit relativement meilleur et être capables de manger, tandis que d'autres peuvent souffrir d'une perte d'appétit et de vomissements, de sorte que la possibilité de manger ou non dépend de l'état ou de la condition physique du patient.
Si le patient présente une réaction au cours du traitement, il doit en informer le médecin à temps. En même temps, il doit veiller à suivre un régime alimentaire scientifique et raisonnable, qui peut être basé sur ses goûts personnels et ses habitudes alimentaires.

Vous devez également adopter un régime alimentaire varié, riche en protéines, en vitamines et en aliments faciles à absorber.
Les patients atteints de cancer ne seront pas toujours dans le même état et évolueront en fonction de la progression de leur maladie et de la taille de leur tumeur, et leur appétit devrait être amélioré ailleurs s'il est médiocre.
Il est bon de pouvoir manger, et bien manger augmente l'immunité, l'endurance et donc la longévité ! Mon père est également décédé d'un cancer du poumon, à trois mois de la découverte, et c'est le manque d'appétit qui a accéléré le processus !
Ces questions et réponses proviennent des utilisateurs du site, elles ne représentent pas la position du site, s'il y a une infraction, veuillez contacter l'administrateur pour la supprimer.